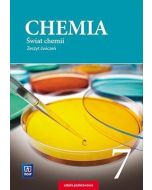
Chemia SP 7 Świat chemii ćw. WSiP

Chemia SP 7 Ciekawa chemia Podr. WSiP
| Typ | Podręcznik |
|---|---|
| Liczba stron | 208 |
| ISBN | 9788302169045 |
| Oprawa | miękka |
przy zamówieniach powyżej 150 zł
Chemia SP 7 Ciekawa chemia Podr. WSiP
Odkryj fascynujący świat nauki z podręcznikiem Chemia SP 7 Ciekawa chemia Podr. WSiP! Ta publikacja Wydawnictw Szkolnych i Pedagogicznych została stworzona z myślą o uczniach siódmych klas szkoły podstawowej, którzy pragną zgłębić tajniki chemii w przystępny i angażujący sposób. Dzięki nowoczesnemu podejściu i klarownym wyjaśnieniom, nawet najbardziej złożone zagadnienia staną się zrozumiałe, a nauka prawdziwą przyjemnością.
Zapewnij swojemu dziecku solidne podstawy wiedzy chemicznej, które są kluczowe dla dalszego rozwoju edukacyjnego. Podręcznik Chemia SP 7 Ciekawa chemia WSiP to inwestycja w przyszłość, rozbudzająca ciekawość świata i wspierająca logiczne myślenie. Przygotuj się na chemiczną przygodę, która zainspiruje do samodzielnych eksperymentów i poszukiwania odpowiedzi na intrygujące pytania.
Główne Zalety Podręcznika
- Przystępny język i klarowne wyjaśnienia skomplikowanych zagadnień chemicznych.
- Bogato ilustrowany materiał, ułatwiający wizualizację procesów i struktur.
- Zadania i ćwiczenia rozwijające umiejętności praktyczne i analityczne.
- Sekcje powtórzeniowe, wspierające utrwalanie zdobytej wiedzy i przygotowanie do sprawdzianów.
- Zgodność z aktualną podstawą programową dla klasy 7 szkoły podstawowej.
Specyfikacja Produktu
| Tytuł | Chemia SP 7 Ciekawa chemia Podr. WSiP |
| Wydawnictwo | WSiP (Wydawnictwa Szkolne i Pedagogiczne) |
| EAN | 9788302169045 |
| Typ | Podręcznik |
| Klasa | 7 Szkoła Podstawowa |
Najczęściej Zadawane Pytania (FAQ)
Dla kogo przeznaczony jest podręcznik Chemia SP 7 Ciekawa chemia Podr. WSiP?
Podręcznik jest idealny dla uczniów klasy 7 szkoły podstawowej, którzy rozpoczynają naukę chemii lub potrzebują wsparcia w zrozumieniu podstawowych zagadnień chemicznych. Jest to kluczowe narzędzie zarówno dla uczniów, jak i nauczycieli.
Czy podręcznik zawiera zadania utrwalające wiedzę?
Tak, publikacja zawiera liczne zadania, ćwiczenia oraz sekcje powtórzeniowe, które pomagają utrwalić materiał i sprawdzić poziom zrozumienia omawianych zagadnień.
Wyszukiwane frazy
chemia SP 7, ciekawa chemia, podręcznik WSiP, podręcznik do chemii, nauka chemii, chemia dla szkół podstawowych, podręcznik klasa 7
| EAN | 9788302169045 |
|---|---|
| ISBN | 9788302169045 |
| Opis wydania | Strony: 208, Format: 17x24 cm |
| Rok wydania | Rok wydania: 2017, oprawa: broszurowa |
| Tytul | Chemia SP 7 Ciekawa chemia Podr. WSiP |
| Wydawnictwo | WSiP |
| ISBN | 9788302169045 |
| Typ | Podręcznik |
| Klasa | 7 |
| Przedmiot | Chemia |
| Zakres | ND |